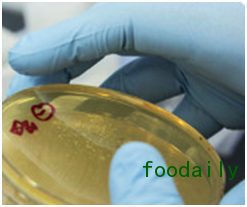

照片来自Ginkgo Bioworks 。
一家从事转基因技术的公司指出,公开性和透明度是基因工程技术在膳食配料领域中蓬勃发展的唯一途径。
Gingko Bioworks的创意总监Christina Agapakis与NutraIngredients就该公司基于生物学的生产系统的发展进行了讨论。这家位于波士顿的公司称自己为“生物公司”,并且称生物技术是“地球上最先进的制造技术”。
Gingko Bioworks使用自动化方法进行有机体设计,具有快速构建原型的特点。采用生物学方法优化酶生产系统,产物可以用于奶酪、药品甚至石磨牛仔裤等多种产品。在食品和膳食补充剂领域,该技术已经用于食品、香料、风味配料以及其它功能性配料的生产。“合成生物学”也已经采用了这种方法,这也是Agapakis感觉可能会模糊不清的方面。
Agapakis说:“我的博士课题就是合成生物学。我将其看作是描述一种特定学术领域的实用术语。虽然我们在实践中使用的工具与之前的没什么区别”。
旧技术,新工具
Agapakis说,使用发酵技术作为生产方法的历史几乎和食物本身一样悠久。她举了某些维生素生产的例子,其基本思想是鉴定某些能够分泌所需化学物质的微生物,然后对其进行修饰,使其更好地产出这些物质或是产出稍微不同的分子。
她说:“这种方式已经用于大量维生素的生产。CoQ10的生产也是如此。几乎所有采用生物方式生产的生物活性分子都可以利用我们的技术进行生产”。
Agapakis说:“从历史上看,生物技术并没有过多地参与食品配料的生产,但是随着成本的下降,它会变得更有意义。我们正在使降低基因工程成本变为可能。”
使用该技术的一个主要问题是如何将其呈现在标签上并传达给消费者。由于对“天然”的概念仍然没有正式的法律定义,一些生产者已经习惯将发酵看作是自然界中的普通过程,进而将以这种方式生产的配料也标注为天然。而反对者则认为,这个过程的一些环节使用了自然界中不存在的物质,例如工程化的微生物。
对于消费者来说,这在膳食补充剂领域中已经不是一个问题,因为合成配料已经在补充剂中使用长达几十年了。但在食品领域,它仍然是一个争论焦点。以香草为例,使用真正的香草豆来生产风味配料的供应商担心它们无法与合成生物学制造出来的更便宜的“天然”香草醛竞争。
对于Agapakis来说,这个答案是明确的:尽可能地采用先进和透明的技术。
她说:“我们十分重视技术的公开性和透明度。我们支持转基因生物标签。我们不希望对转基因成分进行隐瞒。我们的启发实际上来源于人们对食物及其它产品来源的关心。”
Agapakis说:“透明度对于这些技术的发展以及公开化至关重要。
艰苦的公关战
应用转基因技术的一个大问题是该项技术已成为公共关系灾难。转基因技术为使用它的公司带来了利益,但公众本身并未受益,至少公众是这样想的。此外,可以这么说,无论对错与否,与大自然混杂的潜在危险都带来了恐惧。诸如超级细菌泄漏和基因改造食物危险一的世界末日论充斥着推特圈。
她说:“我们认识到,许多关于转基因生物的担忧都远远超出了技术本身,而进入了伦理和商业惯例的问题。我们希望成为一个好的参与者,但我们了解历史,我们知道这是一场艰苦的战斗。”
Agapakis指出:“我说什么都无法缓解所有的担忧。但从我们的角度来看,生物学才是终极的绿色化学。它在一定的环境温度和压力下进行,所用均为食品级原料。企业存在这样的恐惧,就是如果你说产品是转基因的,那么它将被消费者抵制,这就驱使他们开始尝试保守秘密。但我们相信公开透明是削减这种恐惧的唯一途径。”
本文来源为FOODAILY每日食品网,如转载请注明出处,违者必究。








评论